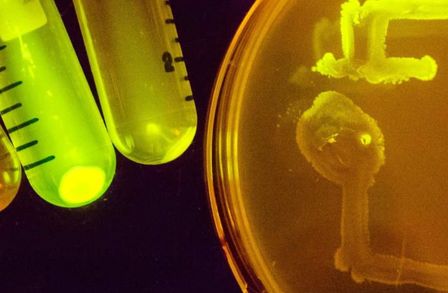

Centres, Networks and Institutes
Centres, institutes and networks
Other Collaborations
Academic staff from the Department of Life Sciences also work with the following centres, networks and institutes across Imperial:
Global Challenge institutes
Cross-Imperial Initiatives
Imperial Networks of Excellence
- Agri Futures Lab
- Artificial Intelligence Network
- Earth Observation Network
- Frontiers of Ultrafast Measurement – Network of Excellence
- Malaria Network
- Marine & Coastal Environments Network of Excellence
- Microbiome Network
- Ocean Plastic Solutions Network of Excellence
- Physics of Life Network
- Space Lab
- Stem Cell Regenerative Medicine Network
- Imperial Network for Vaccine Research
- Vascular Science Network
- Wound Healing and Regeneration Network